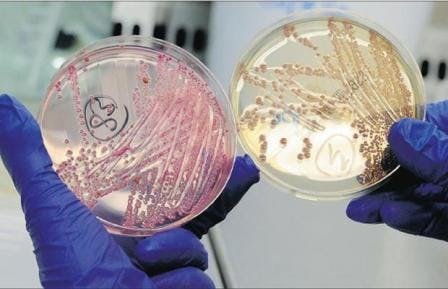

Het garanderen en optimaliseren van voedselveiligheid en kwaliteit is een belangrijke taak van kwaliteitsmanagers. Ook het voorkomen van pathogenen is daar een onderdeel van. Hieronder zeven artikelen over pathogenen die belangrijk zijn voor iedere kwaliteitsmanager.
FreshRecruitment